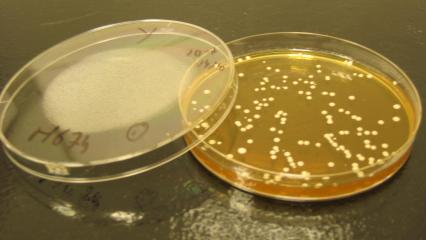

Catalogue
Bienvenue sur le catalogue des formations 2026 du Groupe ICV et laissez vous surprendre par nos nouvelles formations mais aussi nos formations best-sellers depuis de nombreuses années !
Nous sommes à votre disposition pour toute question sur le contenu pédagogique de nos formations (fgras@icv.fr) ou sur les aspects administratifs. (06 77 62 15 31 ou formation@icv.fr)
Nos tarifs s'affichent par stagiaire dans le cas de formations INTER ou par groupe de 15 stagiaires maximum pour les formations INTRA entreprise, pour les durées indiquées.
N'hésitez pas à nous contacter pour construire un parcours de formation, échanger sur la durée des sessions, nous sommes à votre écoute et adapterons au mieux notre offre à vos exigences !
Nos formations sont qualifiantes mais non diplômantes et ne sont pas éligibles au Compte Personnel Formation (CPF).
-
-
Les fondamentaux 2
-
Gagner en productivité 7
-
Une viticulture respectueuse de l'environnement 5
-
En route vers l'agroécologie 3
-
Protection du vignoble 2
-
Cultiver demain 3
-
Innovations et viticulture 2.0 1
-
Bien préparer ses vendanges 1
-
-
-
Les fondamentaux 4
-
Se perfectionner 8
-
Les gaz en oenologie 3
-
La microbiologie des vins 2
-
Les vins rosés 2
-
La préparation au conditionnement 1
-
Spécial "Opérateurs" 2
-
-
-
Les fondamentaux 3
-
Espace de vente 1
-
Se perfectionner 1
-
Spécial "Opérateurs / Dégustateurs ODG" 6
-
-
-
Les fondamentaux 2
-
Se perfectionner 2
-
La métrologie 2
-
L’étiquetage 1
-
-
-
Sécurité alimentaire / HACCP 5
-
-
1
-
1
-
3
-
-
Savoir construire son projet stratégique d'entreprise 1
-
-
3
-
1
-
Espace de vente 2
-
Gestion 2
-
-
-
La bière 3
-
Les vinaigres 2
-